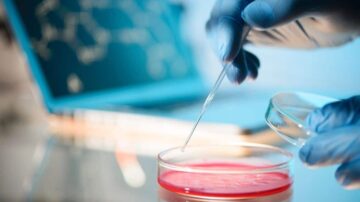
مختبر علوم

يُرجع الباحثون في الإعجاز العلمي للقرآن جذوره إلى الإمام الغزالي الذي اعتبر أن القرآن يحوي “مجامع علم الأولين والآخرين”، و”هو البحر المحيط، ومنه يتشعّب علم الأوّلين والآخرين”، ويعتبر الغزالي أن جميع العلوم داخلة في أفعال الله وصفاته، وفي القرآن شرح ذاته وأفعاله، فمقصد الغزالي من مقولته التعرف على الله من خلال القرآن وما اشتمل عليه من أصول العلوم ومفاتيحها، ثم جاء الرازي ليطبق فكرة الغزالي ويوظف العلوم في معرفة أسرار القرآن والوجود، ولم يسمِّ ذلك تفسيرا أو إعجاز علميا، إنما كان جاريا على نسق علماء كل عصر في الاستفادة من معارف زمنهم وتوظيفها في اختصاصاتهم.
رواج الإعجاز العلمي
ولم يظهر تعبير “الإعجاز” أو التفسير العلمي إلا بعد اكتشاف العالم الإسلامي الهوة الساحقة بينه وبين الغرب في مجال العلوم خصوصا، فتمت العودة إلى القرآن كوسيلة لاستعادة الثقة بالذات والتعويض عن التأخر العلمي لدى المسلمين، لذلك يعلل طنطاوي جوهري (ت:1940م) -صاحب أول وأشمل تفسير علمي- عمله بأنه رأى “أن شباب الأمة المسلمة وبعض أجلّة العلماء، عن العلوم الكونية معرضون”، فوضع تفسيره عسى أن يكون سبيلا ترتفع به مدنية المسلمين إلى العُلا فتفوق الفرنجة في الزراعة والطب والمعادن والحساب والهندسة والفلك وغيرها من العلوم والصناعات.
لكن تفسيره قوبل بالرفض؛ ليس لمبالغاته فقط، وإنما يرجع إلى علة أخرى هي أثر ذلك السلبي على القرآن لا من حيث المبدأ، وإنما من حيث الاستناد إلى نظريات علمية لم تصل إلى القطع فيتم بتغيرها نقض التفسير، وبالتالي الطعن بالقرآن، لذلك قيد المعترضون التفسير بأن يكون بالحقائق العلمية، فمعظم الجدل حول مشروعية التفسير العلمي لم يكن في جوهره موقفا من المبدأ، إنما من نماذجه وممارساته، وهذا يقتضي أن يتجه النقاش فيه إلى مسألة أعمّ -كما يرى أحميده النيفر- وهي التفسير الأيديولوجي للقرآن والذي لا يختلف عنه التفسير العلمي في جوهره.
لذلك لجأ المُحْدَثون من المشتغلين بالإعجاز العلمي إلى إعلان التقيد بالحقائق العلمية القاطعة التي لا رجعة فيها، أما النظريات العلمية فاستخدموها في التفسير العلمي دون الإعجاز (كما يقول زغلول النجار/ موقع أهل التفسير).
وقد لاقى التفسير والإعجاز العلمي رواجا حديثا، وذلك كوجه جديد من وجوه الصحوة الإسلامية التي تستقطب الشباب، وتم استثماره من قبل بعض الدعاة الجدد الذين يبحثون عن أنماط تجذب شرائح لم يستقطبها الخطاب الدعوي المسجدي والتقليدي، وساعد في بروزها توظيف وسائل الإعلام والفضائيات واستخدام التقنية في تبسيط القضايا العلمية وعرضها، ونشوء مؤسسات وجوائز للإعجاز العلمي الذي اتسع ليشمل السنة مع القرآن، وزاد في انتشارها توظيفها في دعوة غير المسلمين إلى الإسلام وادّعاء إيمان كثيرين منهم بواسطة ذلك، مع خلط في هذا المجال بين انسجام القرآن مع العلم المؤثر الأول في الإيمان بالنص وبين ما يُدّعى إعجازا علميا.
وتوسع التفسير العلمي إلى كل ميادين العلوم فراج الحديث عن طب مستخرج من القرآن مرافق للطب النبوي، فضلا عن الفلك وعوالم النبات والحيوان وأنظمة الكون، حتى أصبح في الحديث إسقاط وسخف بالعقول، وأصبح الموضوع شغل من لا شغل له، مع جهل فاضح بقوانين اللغة وأبجديات تفسير النصوص وسياقاتها، بل انتقلت العدوى إلى غير المسلمين فظهر من يدعي الإعجاز العلمي في الكتاب المقدس ويتم توظيفه في التبشير.
خلفيات نقد الإعجاز العلمي
هذه الطفرة المتأخرة في الحديث عن الإعجاز العلمي والشطط فيه أورثت نقدا له شبيها بردة الفعل على طنطاوي جوهري، مأتاه مخاطر الممارسات والتطبيقات لا النقد الجوهري للمبدأ، لذلك غابت المفاهيم العلمية في النقد والتي أهمها ما يتعلق بالموضوع وهو مفهوم الإعجاز، والذي يجمع المتحدثون في تعريفه على شرطية التحدي فيه، كما حصل التحدي بالقرآن أن يؤتى بمثله أو بعضه، والتحدي بالشيء يقتضي معاينته ومباشرة محاولة الخصم إظهار النقص فيه أو الإتيان بالبديل، وهذا لا يُتصور حصوله فيما يسمى بالإعجاز العلمي؛ لأن ما يُدّعى وجوده من علم في القرآن مجهول بالنسبة للمخاطب فبم يتم التحدي؟.
ثم إن الإعجاز صفة ملازمة للقرآن باعتباره كلاما إلهيا، ولا يمكن أن يوجد في عصر دون عصر، ولو كان هناك إعجاز علمي لفصَّله القرآن للناس وهم به جاهلون وتحداهم أن يكتشفوا خلافه، أما ما يجري اليوم فهو حراك بجهد الغير؛ فالعلم المكتشف لم يباشره المسلمون، وما اكتشفه علماء المسلمين لم يدّع أيٌّ منهم كونه تدبرا في القرآن أو اكتشافا فيه رغم معرفتهم العميقة بالقرآن.
يبقى سؤال جوهري حول وظيفة ذكر القرآن لإشارات ذات بعد علمي في النفس أو الكون، فأي وظيفة لتلك الآيات إن لم يوظف العلم الحديث في تفسيرها؟ والإجابة أنها دعوة للبحث العلمي الجدي الذي دعا إليه القرآن عندما وجهنا إلى آيات الله الكونية والشرعية ولم يقل إننا قادرون على اكتشافها من النصوص التي وظيفتها الهداية والتربية الخلقية التي تحض على النظر والعمل ولا تقدم نفسها بديلا لهما.
إن دعاوى التفسير والإعجاز العلمي المعاصرة إنما هي ظاهرة تدل على فقدان الثقة بالخطاب الإسلامي الدعوي التقليدي وعجزه عن اجتذاب الناس، ومن جهة أخرى عجز علماء الدين المختصين عن إقناع شريحة من الناس برؤاهم، ما فتح الطريق أمام دعاة جدد لم يتخرجوا في مدارس العلم الشرعي التقليدية، إنما أتقنوا أدواتها ومصادرها في الوعظ ووظفوا معارف العصر التقنية والعلمية في الدعوة وسط عالم من النجومية صنعته لهم وسائل الإعلام، ما أجج موقف الشيوخ التقليديين منهم، إذ إن الدعاة الجدد أضافوا إلى تطفلهم انتزاع جمهورهم.
لقد كانت ظاهرة التفسير والإعجاز العلمي ظرفية تعكس الوهن الحضاري والثقافة السائدة، وستبقى في حالة مد وجزر وهي الآن في حالة طفرة ورواج سيعقبها زوال وكمون لانكشاف هشاشتها لدى المخدوعين بها وعدم تأثيرها في دفع الحراك الحضاري للمسلمين، بل إنها تؤدي دورا سلبيا خادعا وهو تضخيم وهم الأسبقية واعتبار الإعجاز العلمي نصرا إسلاميا في زمن الهزائم الحضارية.